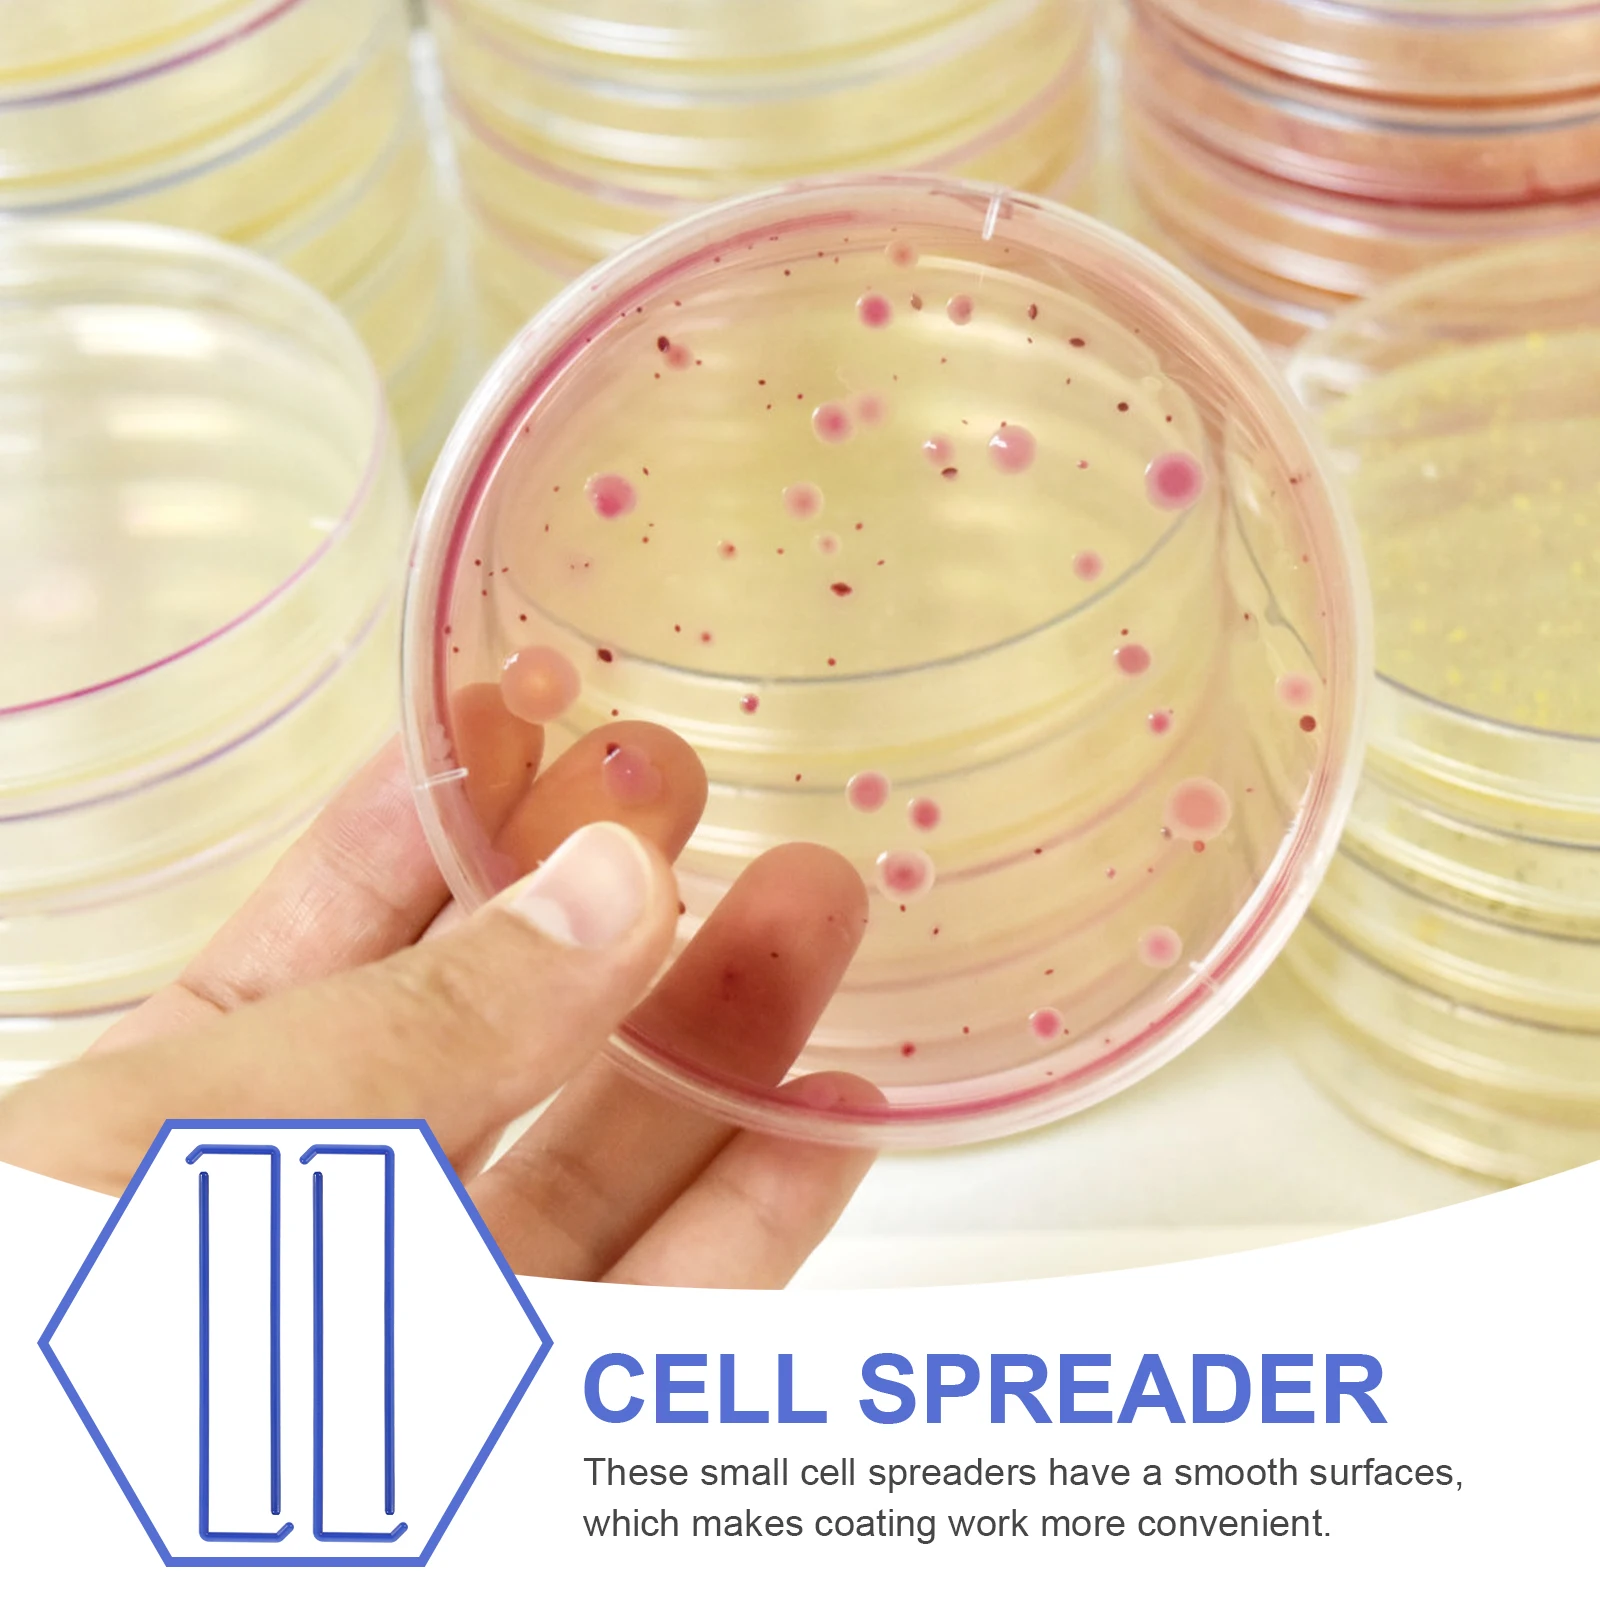

Nylon Waist Bag 2019 Women Belt Bag Men Fanny Pack Fashion Colorful Bum Bag Travel Hengreda Purse Phone Pouch Pocket
Technical Details
Brand Name: | Hengreda |
Color: | black,grey,pink,blue |
Function: | waterproof hiking fanny bag for daily life |
Gender: | Unisex |
Intend use: | hiking running walking travel daypack sports outdoor |
Item Length: | 34cm |
Item type: | Waist Packs |
Keywords: | waist bag fanny pack hip bum bag belt bag Multipurpose Multifunctional |
Main Material: | Nylon |
Material: | nylon |
Material Composition: | Nylon |
Model Number: | S72 |
Package Weight: | 0.11kg |
Pattern Type: | Solid |
Shape: | Pillow |
Size: | 34*15*2 cm |
Strap Drop: | 5cm |
Style: | nylon waist bag belt bag |
Target Audience: | Women Men Bum bag hip bag |
Unique Design: | lightweight |
Price history chart & currency exchange rate
Customers also viewed

$6.53
Women Knitting Walking Shoes Slip-On Mesh Sneakers Lightweight Flat Socks Shoes Loafers Walking Sneakers for Indoor Outdoor
aliexpress.ru
$13.72
XIXIYIN Replacement Silicone Ice gel Earpads for Sennheiser HD280 / EPOS GSP 370 Headset Comfortable/Durable to Wear/washable
aliexpress.ru
$20.44
Парик для косплея Frieren Beyond Journey's End Land, короткие желтые, черные, термостойкие синтетические волосы, кепка для ролевых игр на Хэллоуин
aliexpress.ru
$87.54
Нужен компьютерный стол, 47-дюймовый стол для домашнего офиса, современный простой игровой стол для домашнего офиса, базовый письменный стол
aliexpress.ru
$54.68
Сверхмощная складная регулируемая вешалка для одежды на колесиках, 100 фунтов, хром
aliexpress.ru
$105.26
Сварочный аппарат для пластика 2 в 1, комплект для сварки пластика, комплект для ремонта автомобильного бампера, 4 типа пластика
aliexpress.ru
$38.13
2 шт./компл. женские серьги-кольца, комплект ювелирных изделий, инкрустация цирконом, 30 цветов, комплект ювелирных изделий с кристаллами ярких цветов, позолоченные модные ювелирные изделия, подарок
aliexpress.ru
$8.64
Регулируемый инструмент для позиционирования долбежей для фрезерования круглых отверстий из сверхтолого алюминиевого сплава с деревообрабатывающей угловой резьбой
aliexpress.ru
$1.38
3pcs нержавеющая сталь чары ангельские браслеты подвески ювелирные украшения ожерелья делая выводы DIY ручной работы принадлежностей
aliexpress.ru
$2.94
Бен Дранкин Сумка для обеда Бенджамин 4 июля Портативная коробка для завтрака Школьная сумка с графическим дизайном Ретро Оксфорд Термальные сумки-тоут
aliexpress.ru
$2.67
A20F-(упаковка из 2 шт.) Шип-бампер/малючая собака для STIHL MS170 MS170C MS180 MS180C MS171 MS181 MS211 017 018 018C 019T 021 023 025
aliexpress.ru
$1.79
SEEDEW Premade Manga Elf Lashes Наращивание ресниц в форме пера Air Series Легкие накладные ресницы
aliexpress.ru
$11.23
Новинка 2023 года, летние мужские рубашки с кошачьим принтом, гавайская рубашка, мужская повседневная одежда с короткими рукавами, модные винтажные уличные топы
aliexpress.ru
$1.38
Черная металлическая дверная полоса автомобиля, крепеж для отделки панели, зажим для багажника, багажника, фиксатор бампера, металлические зажимы, зажимы типа V
aliexpress.ru
$11.81
Переходной кабель PCI Express, 90 градусов, 50 см, удлинитель PCI-E 3.0 для видеокарты, медный провод, стабильная передача, предотвращает ослабление
aliexpress.ru
$16.68
2024, зимняя куртка-пуховик, женская модная короткая теплая куртка Sustans, стеганые парки для женщин, верхняя одежда, пальто, парки на хлопковом пуху
aliexpress.ru
$2,060.21
High Pressure Air Pump Air Respirator Diving Gas Cylinder Air Pump 30mp Positive Pressure Fire Compressor
aliexpress.ru
$12.01
Gamera: guardian of the universe T-Shirt essential t shirt funny gifts customizeds plus size men clothing
aliexpress.ru
$1,240.77
New Chinese-style entrance cabinet, entrance partition decorative cabinet, simple household
aliexpress.ru
$10.76
Music Toys Children's Drum Kids Marching Band Youth Drums Metal Baby Red Musical Toddler Snare
aliexpress.ru
$1.44
20 Pcs Coating Rod Experiment Cell Spreader Laboratory Tool Plastic Wide Spreading for Sticks Small Spreaders
aliexpress.ru
$10.84
Watercolor Silhouette The Sword In The Stone Merlin and Madam Mim Tank Top Gym man Working vest Men's t-shirt
aliexpress.ru
$1,141.78
New HD MI to R F Digital Modulator DVB-C 8HD MI Input H264 Video Encoding Dvb-t Modulator ATSC ISDBT
aliexpress.ru
$2,000.00
Customized Food Truck Mobile Catering Trailer Outdoor Mobile Beer Ice Cream Coffee Cart Food Trailer With Fully Equipped
aliexpress.ru
$1.93
Horse Grooming Brush Stainless Steel Hairbrush for Cattle Livestock Cleaning Tool Removing Mud Dirt from Animal Coat
aliexpress.ru
$1.60
2 Pcs Artificial Maple Leaves Stems Faux Fall Decoration Picks Realistic branches for Thanksgiving Harvest Parties
aliexpress.ru
$1.48
Clay Material Mirrors DIY St Small Desk Frameless Portable Bedroom Tabletop Vanity Acrylic Irregular Easy Maintain Decorative
aliexpress.ru
$27.31
Наплечные ремни для рюкзака регулируемый дорожный рюкзак 17 дюймов наплечный рюкзак вместительные рюкзаки с индивидуальным принтом
aliexpress.ru
$14.80
Аккумуляторный блок для Oculus Quest 2, 5000 мАч, перезаряжаемый расширенный внешний аккумулятор с RGB-фонариком для Oculus/Meta Quest 2 гарнитура
aliexpress.ru
$23.84
Высококачественный коврик для приборной панели автомобиля Kia K3 Cerato 2019 2020 2021 2022, солнцезащитный козырек, защита от фотоэлементов, ковры, защита от УФ-излучения, интерьер
aliexpress.ru
$11.96
Металлический карбюратор для замены высококачественный лучший отличный двигатель для генератора Robin ey15 EY20 комплект карбюратора 2018
aliexpress.ru
$2.76
Силиконовый чехол для телефона Xiaomi Poco M5 X3 X4 X5 NFC M3 C40 Pro MI 12 11 10T 12T Lite Note 10
aliexpress.ru